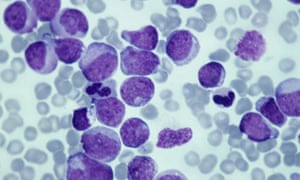

Researchers are developing tests that could make cancer detection so painless that it becomes part of routine check-ups, experts said, as new developments in such “liquid biopsy” technology were presented at the world’s largest cancer conference in Chicago this weekend.
Collecting tumor tissue through biopsies is considered the gold standard for diagnosing and treating cancer. However, necessary surgery is often invasive and sometimes unsuccessful.
That has fueled interest in technology that uses blood samples to examine bits of DNA shed into the bloodstream by tumors. The hope, researchers say, is to save patients the pain of surgery, monitor tumor growth to tailor treatment, and ultimately to save lives.
“It’s fair to say that if you could detect all cancers while they are still localized, you could diminish cancer deaths by 90%,” said Dr Bert Vogelstein, a professor of oncology at Johns Hopkins School of Medicine who co-authored a study presented at the American Society of Clinical Oncology (ASCO) in Chicago.
“But that’s a theoretical figure. The available data suggests that it’s going to take quite a while, and there are a lot of obstacles to overcome.”
Like all cells, cancerous cells shed DNA as they die. Tests in development examine these bits of DNA in the bloodstream, finding mutations in already diagnosed cancers or, experts hope, diagnosing cancer early.
Part of the challenge in developing such tests is scale. Pieces of DNA represent a tiny portion of a blood sample. Pieces of cancer DNA represent an even tinier sliver of all the DNA present in blood.
Pieces of genetic material, called “cell-free DNA”, are found in blood plasma. But plasma contains cell-free DNA from all over the body – not just cancer. In some cases, cell-free DNA from cancer represents just 0.1% of all cell-free DNA, new research has found. That makes the search “a needle in a haystack”.
One of the studies presented at ASCO sequenced 100 times more data than ever before. Using such “high-intensity” sequencing, researchers from Memorial Sloan Kettering CancerCenter scanned “regions” of the genome up to 60,000 times to look for 508 specific genes.
Dr Pedram Razavi and his research team collected blood samples from 124 patients with metastatic breast, non-small cell lung or prostate cancer. Biopsies were collected to provide a baseline, and researchers also sequenced each patient’s white blood cells to rule out benign mutations.
In 89% of the patients, researchers identified at least one gene mutation. The highest success rates were for breast cancer patients, in whom researchers were able to find 97% of gene mutations.
Ravazi said simple tests to screen for cancer were “a very long way” from development, but the new research brought doctors one step closer. “This is a promising first step in patients with metastatic DNA,” he said, referring to advanced cancer patients.
Another abstract presented at ASCO took the opposite approach. US and Australian researchers at Johns Hopkins and the Walter and Eliza Hall Institute of Medical Research in Melbourne screened 119 pancreatic cancer patients for just one mutation found nearly all pancreatic cancers.
Though only four patients had advanced cancer, researchers found cell-free DNA in all of them. In patients with stage two cancer, the largest group, researchers found cell-free DNA in 54.5% of 99 cases. Authors said tests “showed promise” for screening, and could help guide treatment.
One of the researchers, Peter Gibbs, said he could envision that within five years, people would receive tests that search for about 20 cancer gene mutations.
“It’s potentially very close by,” said Gibbs. “The potential impact on screening and prevention is huge.”
[Source”cnbc”]